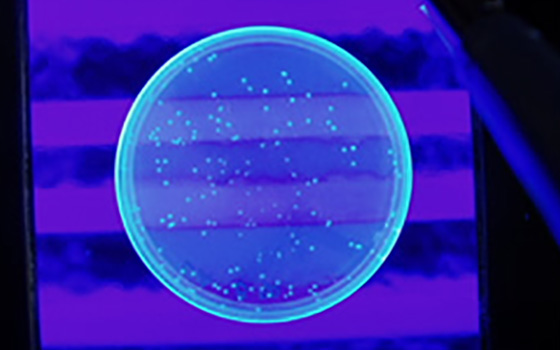
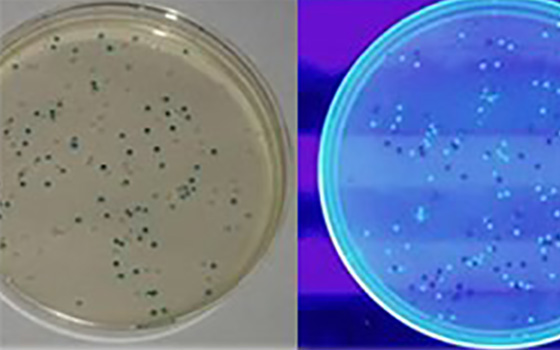

We support science education.
In order to nurture human resources who will lead future biotechnology, we develop and publish educational teaching materials.

Experiment Kit for DNA Extraction
Extract visible and sufficient amounts of DNA from bird livers.
For more information
Experiment Kit for Genetic Recombination (Basic Version)
Learn genetic recombination process safely and easily.
For more information
Electrophoresis Experiment Kit
Experience DNA cutting and agarose gel electrophoresis.
For more information
Experiment Kit for Genetic Recombination (Standard Version)
Learn genetic recombination process safely and easily.
For more information




